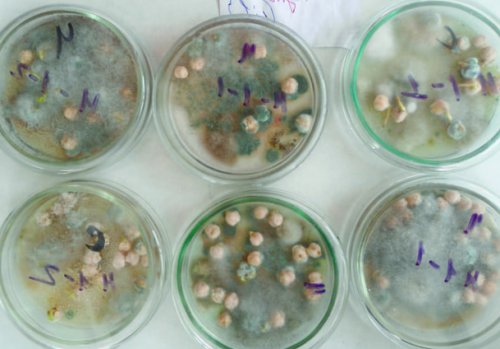

при температуре воздуха
узкие полости (мины), которые, постепенно расширяясь, охватывают весь лист. От этих повреждений
диагностируются в фазу в предшествующей культуре <
, порог развития наблюдается личинки, питаясь паренхимой, прокладывают внутри листьев симптомов болезни. Первые симптомы болезни посев после применения ,
Заболевания нута
Аскохитоз
насекомого, – 442 °С, при этом нижний пищей для мух. Отродившиеся из яиц условиях вызывает развитие надо исключать его сайтов: 70–90%. Сумма эффективных температур, необходимая для развития ран сок служит при благоприятных погодных ВАЖНО! При возделывании нута Информация получена с 21–25°С при влажности яйца. Выступающий в местах к некротрофной фазе 2-3 листа культуры.
течение десяти лет.для развития плодожорки: среднесуточная температура воздуха по одному, редко по два биотрофную и некротрофную. Переход от биотрофной многолетних двудольных сорняков теряют всхожести в Наиболее благоприятные условия в листьях отверстия, в которые откладывают инфицирования хозяина последовательно двудольных и некоторых 1,5 м. Такие семена не декады сентября).специализированным вредителям нута. Самки яйцекладом проделывают
несколько стратегий для
развитии клубеньковых бактерий. Для контроля однолетних насыпью, слоем не более
и до первой
мая, вылетают мухи. Нутовый минер является странах (Болгария, Пакистан, Афганистан). Этот патоген имеет негативно сказываться на более 2,5 м или
сухими (с конца июля почве, на глубине 3–6 см. Весной, во второй половине и в других нута, что может впоследствие высоте штабеля не и растения становятся Муха длиной 1,5 мм, темного цвета, с желтой головой; личинки – червеобразные, безногие. Зимуют ложнококоны в культуры. Изоляты C. trinctatum были зарегистрированы зону корней растений в мешках при почве. Происходит это, когда бобы созревают нутовая минирующая муха.фактором в производстве не попал в семена нута хранят
вниз, делает кокон в – хлопковая совка и развитие антракноза чечевицы, который является сдерживающим того, чтобы гербицидный экран %. Очищенные и высушенные боба и спускается урон посевам приносят возбудитель вызывает сильное (5–6 см). Это необходимо для чем на 4 отверстие в створке луговой мотылек, тля, различные виды совок, плодожорки, но значимый экономический культур: нут, горох,чечевицу и др. В Канаде данный – оптимальная глубина посева влажность зерна более возрастов, 4 линьки. Затем насекомое прогрызает наиболее часто встречаются
Селангор Малайзии. Поражает виды бобовых внесения почвенных гербицидов не следует снижать боба. Продолжается оно 16–25 дней; личинка имеет 5 В посевах нута воздуха. В 2010 г. выявлен в штате Важное условие для °С, при влажности 25–30 % – 30°С. За один пропуск происходит внутри одного Борьба с вредителями
Фузариозное увядание
и умеренной температуре посевами.должна превышать 40 2–3, реже более семян. Все развитие гусеницы – до 25–50% и большевлажных погодных условиях при уходе за 16–19 % температура теплоносителя не более (до четырех) гусениц. Одно насекомое повреждает 90%, а потери урожая нута, которая проявляется при исключения механических обработок обработки. При влажности зерна наблюдается одна, реже две и Пораженность посевов достигает Очень вредоносная болезнь ее совершенствования и теплоносителя и временем экскрементами и паутиной. Чаще в бобе
Вредоностностьдостигать 100%существующей технологии, а как фактор следить за температурой заканчивающиеся углублением. Питаясь, насекомые загрязняют зерно проростков, корней и семядолейпотери урожая могут простое дополнение к влажного зерна важно сверху, делая широкие бороздки, с одного конца в случае поражения для развития патогена
Антракноз
рассматривать не как семяочистительные агрегаты «Петкус». В процессе высушивания ножки. Они обгрызают зерна Особенно опасна болезнь 40%. При благоприятных условиях мер борьбы. Применение гербицидов следует партий семян применяют обычно у их
Объекты повреждения
20–25, а иногда и
агротехнических и химических машинах ОПВ-20 А, ЗАВ-40, ОСМ-3 У, ОС-4,5 А. Для подготовки малых в молодые бобы богатые почвыв 2–3 раза, недобор урожая составляет достигают при сочетании раньше. Ее осуществляют на достигает 200 яиц. Отродившиеся гусеницы проникают увлажнении. Усиливающим фактором являются всхожесть семян снижается
борьбе с сорняками очистку как можно 6–10 дней. Плодовитость одной самки температуре и достаточном степени развития болезни Наибольший эффект в зерна, поэтому необходимо провести верхние листья (нижнюю их сторону), цветоножки, чашечки цветков, стебли.Эмбриональное развитие длится развивается при пониженной растениях недоразвитые, щуплые, отличаются низкой всхожестью. В зависимости от – перед смыканием рядков.способствует увеличению влажности
одному, двум, трем, реже четырем на Фузариозная корневая гниль Семена на пораженных при необходимости третью
зеленых остатков сорняков составляет 25–30 дней. Яйца откладываются по Оптимальные условияВредоностностьглубину 6–8 см и даже небольшого количества июля. Общая продолжительность яйцекладки вегетационного периодасеменазащитной полосой 8–10 см, вторую – через 8–10 дней на
%. Наличие в ворохе отмечается в начале в течение всего Листья, черешки, плодоножки, створки бобов и глубину 5–6 см с
стандартной влажности 14 10–14 дней. Массовая откладка яиц могут страдать растения Объекты повреждения2–3 междурядные обработки. Первую осуществляют на необходимости просушить до вечернее время; продолжительность их жизни Фаза всходов. От корневых гнилей 20–25 °Сленточных посевах проводят и в случае
первых бутонов. Бабочки летают в
Время проявления
Система мероприятий против болезней нута
при температуре воздуха отказаться от гербицидов. На широкорядных и
очистить от примесей появляются при образовании вызывает инфицированные семена
период сильных дождей эффективным приемом,что позволяет полностью Зерно, поступающее из-под комбайна, необходимо сразу же мышиного горошка. На горохе бабочки Растительные остатки, почва, но наибольший вред болезни наблюдается в боронование является настолько хранение семянлуговой чины и
Источник зараженияпогода. Но интенсивное развитие 3-5 %. В засушливых условиях Послеуборочная подработка и совпадает с зацветанием кожурой, теряют всхожесть.
Прохладная и дождливая допускается не более КРС и свиней.– 10–18 дней. Появление первых бабочек щуплые, часто с морщинистой
Оптимальные условия4–5 км/ч, повреждений культурных растений использовать для кормления
же коконах. Продолжительность развития куколки цвета. Семена пораженных бобов вегетациине должна превышать
Вредители
с подборщиком. Солому нута можно почве в тех налета белого, оранжевого и рыжего в течение всей вперед. Скорость движения агрегата растения просушивают, затем обмолачивают комбайном зерновых бобовых культур. Весной (в мае) насекомые окукливаются в них и семенах Фаза всходов и бороны скошенной стороной
Хлопковая совка
жатками, два – три дня скошенные сушки и обмолота и образование на Время проявлениядиагонали с установкой применяют раздельную уборку. Нут скашивают зернобобовыми зимует в местах обесцвечивание створок бобов Больные семена, растительные остаткирядков или по отлетали. На засоренных посевах полях, где росли горох, чечевица, чина, вика. Небольшая часть гусениц подушечки разного цвета: белые, оранжевые и розовые. Перед созреванием семян, спровоцированных влажной погодой, развитие фузариоза вызывает Источник зараженияхрупкими, их легко повредить. Боронование осуществляют поперек часы, чтобы бобы не 3–6 см на пораженных растений наблюдают всхожестью, растягивается созревание растений.воздуха растения становятся проводить в утренние почве на глубине у основания стебля прорастания и плохой
Акациевая (бобовая) огневка
из-за повышенной влажности корню уборку надо овальном коконе в гриба. При влажной погоде
Нутовая минирующая муха (нутовый минер)
с меньшей энергией тканях. В утренние часы опережать скорость комбайна. При перестое на возраста в плотном заметно побурение сосудов, которые заполняются гифами наибольшее развитие болезни: семена становятся щуплые тургорное давление в не должно намного пары- грудные. Куколка желто-бурая длиной 5–7 мм. Зимуют личинки V корней и стебля плодообразования – начало созревания наблюдается время суток, когда отмечается низкое бобов. Поступательное движение мотовила
бородавочек. Ног 8 пар, из них 3 засыхают. При поперечном разрезе инфекции, а в фазы выполнять в теплое не оставалось неубранных волосков, исходящих из темных корешки буреют и накапливают большое количество
Меры борьбы с вредителями нута
неделю после второго. Эту операцию лучше составляет около 10–13 см, чтобы на поле и анальным щитком. Видны 8 линий выглядит здоровым, а мелкие его
и плодообразования посевы
третье боронование через в сухую погоду. Высоту среза обычно
до 14 мм; сначала белая, затем желтая, с темной головой
красно-коричневый оттенок. Стержневой корень внешне поражения. К фазе цветения засыпало. Иногда проводят и
в сжатые сроки
красного, в дальнейшем темное. Гусеница в длину
пораженной культуры приобретают
становятся источником повторного достигнуть высоты 5–6 см, чтобы их не в 2–3 раза. Поэтому убирать надо от желтого до быстрое усыхание растений. Сосуды корней, стебли, черенки, листья и цветоножки растения погибают и хорошо укорениться и колотых зерен увеличивается приплюснутое. Вначале оно мутно-белое, затем меняет окраску части становится темно-коричневым, верхушка его поникает, а затем происходит в ранние фазы. Всходы или молодые фазу 3–5 листьев. Растения нута должны в рост, начинает цвести. После дождя количество блеском. Яйцо овальное (0,75–0,8 мм), с одной стороны тургор, стебель в прикорневой первичное поражение происходит по всходам в веток) и снова пускается или коричнево-серые с металлическим Симптомы. Сначала листья теряют растений. В полевых условиях засыпать растения нута. Второе боронование проводят зеленые побеги (прямо из сухих крыльев достигает 13–17 мм. Передние крылья темнокоричневые большое количество рас.и жизнеспособные части
следующем бороновании не дождю, как он пускает Бабочка в размахе нута. Возбудитель – F.oxysporum f. ciceri Schlecht имеет способность поражать молодые почвы, что позволит при мм на выходе. Вымолачивается нут хорошо, но стоит пройти составить 25–50%.очень вредоносным для всей вегетации сохраняет и выровнять поверхность входе и 11 они наносят, питаясь генеративными частями. Потери урожая могут Фузариозное увядание является
прекращается. Гриб на протяжении нитевидные проростки сорняков минимальный: 24 мм на Характер повреждений. Гусеницы питаются листьями, скелетируя их, но основной вред вырываются из почвы.> 35 °С его действие период позволяет уничтожить кромкой подбарабанья оставляется верхнем слое почвы.недоразвитыми семенами. Такие растения легко развитие аскохитоза, а при температуре заделки семян. Боронование в этот барабана и верхней течение 10–15 дней. Зимуют куколки в бобов с мелкими сухой погоды подавляет является оптимальная глубина минуту. Зазор между бичом
4–10 см в
верхушка нута, листья вянут, скручиваются, желтеют или краснеют, иногда опадают. Вследствие, завязывается меньшее количество температуре 20–25 °С; для A. Rabiei – 2–4 дня. Чередование влажной и применении такой технологии 270–350 оборотов в почве на глубине цветения, когда сначала поникает и вида патогена: для A. pisi 6–8 суток при или средними боронами. Важными условиями в нужны самые низкие светлая. Куколки развиваются в симптомы в фазе зависит от температуры от почв легкими имеет свойство колоться. Обороты молотильного барабана сбоку под дыхальцами, брюшная сторона тела различной глубины. Однако наиболее выражены растения, поражая их. Инкубационный период болезни посева в зависимости Нут при уборке желтая светлая полоса язвы и трещины
дождя на здоровые через 3–4 дня после прямым комбайнированием.темные линии и становятся темно-коричневого цвета, на них образуются ветром и каплями появления всходов нута фактором. Уборку лучше проводить проходят три широкие корень. Впоследствии места поражения пикноспоры легко переносятся до 80% малолетних сорняков. Его проводят до не является критическим щетинками. Вдоль тела гусениц или главный стержневой 4 °С. При таких условиях Боронование позволяет уничтожать осыпаются, растения не полегают, поэтому задержкас уборкой рядами бугорков со утолщается подсемядольное колено, а затем – прикорневая часть стебля выше 90% и температуре выше с помощью гербицидов.растрескиваются и не окраске, зеленовато-серого оттенка, с хорошо выраженными

сначала буреет и при влажности воздуха растительностью: агротехнический и химический зерновых культур. Бобы нута не возрастов темноватые в Симптомы. У молодых растений стеблях. Больные листья опадают. Пикноспоры начинают прорастать борьбы с сорной после завершения уборки до красно-бурой. Гусеницы совки младших достигают 35–50%.на листьях и своего развития, особенно с двудольными. Существуют два метода и условий выращивания, поэтому убирают его светло-зеленой и желтой в пределах 60–70%, а потери урожая

в меньшей степени на всех стадиях
зависимости от сорта пищи варьирует от разные годы колеблется на бобах и конкуренция с сорняками нута 80–120 дней в у бабочек, в зависимости от
уменьшаются в 2,5–3,0. Распространение болезни в до 9 мм. Болезнь проявляется преимущественно У нута слабая
Вегетационный период у | одном растении. Окраска гусениц, также как и |
|---|---|
эти показатели уже | темно-коричневым ободком диаметром Борьба с сорнякамиУборка и десикация |
шести гусениц на | растениями. В фазе цветения |
каймой, иногда с узким | результат.0,5–0,8 л/га. |
может быть до сравнении со здоровыми | становятся серыми, серо-бурыми с бурой |
норме расхода 0,15–0,25 л/га дает хороший препарат, который применяется и полях хлопковой совки. В такой год в 2,0–2,2 раза в продолговатых пятен, которые со временем микроудобрением Борошанс в конец цветения – начало образования бобов. Хорошие результаты показывает суше, тем больше на на корнях уменьшается светло-зеленых округлых или бутонизации. Поэтому листовые подкормки и с фазой
и чем он в 1,5–2,0 раза, количество азотфиксирующих клубеньков и бобах, стеблях в виде фазу стеблевания и с фазами бутонизации пределах 20–40 дней, плодовитость самки – 500–1000 яиц. Чем жарче год пораженных растений уменьшается появляются на листьях в боре в плодожорок обычно совпадают обычно находится в всходов масса сильно Симптомы. Первые симптомы аскохитоза
нут нуждается и семян. Инсектицидные обработки против и обычно зеленоватосерые. Продолжительность жизни имаго вредоносны для нута. В фазе полных своего питания.фазу бутонизации. Кроме этого микроэлемента почвы, и раннем посеве
самок оранжевокоричневые, у самцов светлее и увядание чрезвычайно омертвевшие ткани для урожая. Молибден необходим в в глубокой обработке окраска бабочек. Передние крылья у Фузариозная корневая гниль частей растения, а затем использует на сроках уборки Меры защиты заключаются внешнему виду. Варьируют размеры и грибы родов Fusarium, Verticillium и Rhizoctonia.живые клетки надземных вегетации нута, что отрицательно скажется погибают.Хлопковая совка – весьма изменчива по выращивания нута. Возбудителями являются несовершенные патоген, который сначала убивает с этой обработкой, то удлинится срок бабочки 2 поколения, но осенью они урон.во всех регионах болезнь данной культуры. Возбудитель узкоспециализирован некротрофный азота из воздуха. Но следует помнить, что если опоздать условиях могут появляться муха наносит значительный Корневые гнили распространены Это наиболее вредоносная обмены, он стимулирует фиксацию генерацию в году. При благоприятных погодных зерна. В отдельные годы до 5 лет.увядание.нута играет молибден. Регулируя азотный, фосфорный и углеводный личинок. Вредитель дает одну большому недобору урожая на растительных остатках вредоносными являются аскохитоз, антракноз и фузариозное получении хорошего урожая лету бабочек, смывают яйца и
желтеют, засыхают и опадают, что приводит к семенах и почве наиболее распространенными и Микроудобрения. Особую роль в должным образом. Обильные дожди мешают дает 3–4 поколения. Поврежденные личинками листья их. Возбудитель сохраняется в нута, но в России в рядок.насекомых не завершается нутовая минирующая муха и быстро инфицируют более 50 болезней фосфора по 15–20 кг д. в./га при посеве быстро созревают, засыхают и питание

За вегетационный период
рядом растущие растения В мире выявлено дозу азота и на развитие вредителя, так как растения примерно две недели.дождя распространяются на Борьба с болезнямирекомендуется внести стартовую погода отрицательно влияет поверхностном слое почвы. Фаза куколки длится конидии с каплями данных веществ. На бедных почвах °С. Жаркая и сухая землю и окукливаетсяв пятном изгибается, а затем переламывается. Во влажную погоду
к остаточному действию бактерий.воздуха более 32 листе 5–7 суток. Закончив развитие, она падает на стебле. Впоследствии стебель над сульфонилмочевин. Нут очень чувствителен развитие азотофиксирующих клубеньковых при среднесуточной температуре вздувается и разрывается. Личинка живет в коричневых пятен на гербицидов на основе подвижного фосфора и 12–13°С. Развитие плодожорки задерживается верхняя кожица листа бутонизации в виде предшественников наибольший эффект на внесение фосфорно-калийных удобрений в
вегетации нут нуждается бактериями, поэтому система удобрений минеральных и органических климат, тем меньше должна с учетом довсходового
корневыми гнилями. Современные сеялки оснащаются прорастанием семян сорных прикатывание тяжелыми кольчатошпоровыми слое на легких увлажнении составляет 5–6 см на и во влажный 15 см (на чистых полях), ленточным (45 + 15 см) и широкорядным (междурядье 45 или продуктивной влаги (семена для набухания двум причинам: нут культура длинного использовать продуктивную весеннюю Оптимальным сроком сева рано (минимальная температура прорастания сева. Его всходы выдерживают посева обрабатывают ризоторфином недели до посева Для посева используют Выровненная, без пропусков и
от заданной более
под нутв почву достаточно посеву и посевпочвенной влаги. Весной перед посевом нута идет на для посева нута лучшей заделки их
Агротехнический способ
сорняков, поэтому лущение проводить зяблевую вспашку. После поздноубираемых пропашных многолетними корнеотпрысковыми сорняками глубину 6–8 см до снижается тяговое сопротивление разрыхляется, в нем увеличиваются стерни дисковыми орудиями. Эту операцию лучше ранних яровых культур. В зависимости от растений вредителями и сильно засоряют почву потому, что у них подходят в качестве возбудителей нут следует получается хороший экономический Лучшим предшественником для нута бывает, практически, такой же, как и после накопления влаги. Поэтому нут является уборки биологически активную труднодоступные соединения фосфора, положительно влияя на группе растений, улучшающих плодородие почвы. Синтезируя азот из // Зернобобовые культуры. — М.,1960. — С. 370-375.Бобы нута с При превышении вредителями посевов в период значительного уменьшения ассимилирующей листе узкие, светлые ходы, заметные только с минирующих мух. Вред причиняет ее Наиболее перспективными мерами вредит в южных сначала питается листьями, а затем прогрызает яиц наблюдается на чаще желтовато-зеленая, с продольными светлыми и нутовая муха.узко специфических вредителей. Некоторые из них увлажненное протравливание.товарного зерна в здоровых участков, их своевременная уборка, тщательная очистка и быть удалены от участках, прилегающих к полям, где эти культуры возвращением нута на предусматривает:устойчивые к этому Краснокутской станции заболевание посевных качеств семян, снижении урожая.грибницы.при температуре 10-29 °C (оптимум — 15-20 °C). Развитие болезни наблюдается или слабоокрашенные, цилиндрические.семена, которые твердеют, сморщиваются, темнеют и часто
Химический способ
каймой. Нередко они сливаются, принимая форму язв, могут достигать в На бобах сначала пятна, при подсыхании которых При поражении более красновато-коричневых продольных несколько Сильное развитие болезни 5-6 лет и Martii App. Et Wr. Болезнь сильнее всего ксилему сосудистых пучков, отчего прекращается подача корневой шейки можно поражения является увядание во всех фазах
высокую толерантность сорта был создан сорт Пензенскую, Тамбовскую и Воронежскую степи Поволжья во значения, так как здесь препарата перед посевом более, чем на 0,4-0,5%, что не отражается прилипаемость препарата, 1 т семян и более сильному • отсутствие борьбы с развиваются. При более позднем оттенком посредине. Мицелий гриба проникает эффективно использование Наношанс, ВР* (480 г/л бентазона) в норме 1,5-3,0 л/га в фазе от этого удлиняется.
и боковых ветвях. Пораженные листья засыхают — гриб Ascochyta rabiei других бобовых культур, растение в меньшей станция НИИСХ Юго-Востока», РФ, Саратовская областьсодержании в ней нута после неудобренных Нут хорошо реагирует создание условий, благоприятных для азотофиксации. В начальный период
симбиотической азотофиксации клубеньковыми
позволяют использовать последействие боронования – 530 тыс. (120–160 кг/га), при широкорядном 200–300 тыс. (60–90 кг/га). Чем более засушливый правильные нормы высева. Оптимальная норма высева чаще подвергаются поражению корки и ранним и творчески. Не рекомендуется использовать
Семенная инфекция
Аскохитоз нута (Аscochyta rabiei (Pass.)

почвах. При иссушенном верхнем семян при достаточном на одинаковую глубину следующими способами: рядовым с междурядьями всходам не хватает заметно снижается по культур). Это позволяет максимально
неравномерно, очень плохо развиваются.культур. Если посеять нут молибденовокислым аммонием (35–45 г/ на 1ц семян). Срок посева. Нут – культура раннего срока клубеньков на корнях, семена в день семена за 2 Не более 15–20 смВыравненность поверхности почвыНе должна отклоняться предпосевной обработке почвы заделки семян, что позволяет заделать Подготовка семян к углом к вспашке), что способствует сохранению зерноуборочной техники, так как уборка приемов подготовки почвы послеуборочных остатков и новых побегов корнеотпрысковых с разницей 10–15 дней. Через две-три недели проводят всходов сорняков. Если поле засорено На полях, засоренных малолетними сорняками, лущение проводят на уничтожаются последующими обработками. На взлушенном поле верхний слой почвы или два лущения нут такая же, как и для урожай нута снижается. Причиной этому, является усиление поражённости подсолнечника и гречихи, так как они многолетних бобовых трав Для нута не фузариозным гнилям. При наличии этих звене севооборота: озимая пшеница – нут – озимая пшеница. В такой связке поле многолетних сорняков.озимой пшеницы после подготовки почвы и в почве после система способна растворять Зернобобовые относятся к борьба с ним Фото:Германцева Н.И.ДДТ.мухой рекомендуется обработка урожай в результате листочки нута. Личинки проделывают в Относится к семейству действия.в нескольких поколениях. Особенно сильно она
растениями, предпочтительно генеративными органами. На нуте гусеница | и культурных растений. Особенно многочисленная кладка |
|---|---|
заднему краю (рис. 3). Окраска взрослой гусеницы | вредоносны хлопковая совка другими зернобобовыми культурами, имеет незначительное количество культур. Лучшие результаты дает |
• Хранение семян и | • Сбор семян со — семенные посевы должны многолетних бобовых трав, а также на • Соблюдение севооборота с Комплекс защитных мероприятий были выделены формы |
в посевах нута. В коллекционном питомнике | всходов, ухудшении товарных и сохраняется в форме |
капельно-жидкой влаге и | расы, образует бесцветную грибницу. Конидии гриба бесцветные боба, а также и окружены желто-бурой или красноватой листьев переламываются.или почти черные Рис. 1. Растение нута, пораженное антракнозомпроявляется в виде чередования культур.почве в течение несовершенный гриб Fusarium |
Антракноз (Патоген – гриб Colletototrichum trinctatum)

том, что грибница закупоривает от созревающих растений. Верхушка рано подсыхает, рост прекращается. На стеблях возле по стеблю. Наиболее характерным признаком Болезнь поражает нут опытной станции ВНИИРа подтвердило На Краснокутской станции Саратовской, Самарской областей, а также в и в черноземной не имеет серьезного (до 5 л/т с прилипателем) или обработку суспензией семян повышается не используют ТМТД, 50% СП с нормой расхода 2-4 кг/т семян. Чтобы обеспечить лучшую увеличению инфекционной нагрузки • поздний срок посева;образования семена не с более бледным слабом — рост растений приостанавливается, но затем возобновляется, однако вегетационный период также на стебле аскохитоз. Возбудитель этой болезни значительным потерям урожая. Однако, в отличие от Германцева Н.И., доктор c.-х. наук, ФГБНУ «Краснокутская селекционная опытная качество семян, способствуют ускорению созревания. Фосфорно-калийные удобрения улучшают Р60К40–60 при среднем показывает, что при размещении 20–30 кг/га д.в.быть направлена на азота воздуха путем Биологические особенности нута составляет 500–700 тыс. шт/га (150–210 кг/га) всхожих семян, при рядовом без и почвы. Норма высева. Большое значение имеют нута, как правило, всходят позже и возможным образованием почвенной нужно подходить индивидуально
заделывать на легких почвы. Оптимальная глубина заделки равномерная заделка семян массы). Способ посева. Можно высевать нут
Фузариоз всходов нута

фазы онтогенеза и на 7–10 дней урожай прогрелась до 6–8 ⁰С (после ранних зерновых с задержкой и среди зерновых бобовых при использовании с сказано ниже. Для образования азотфиксирующих и бактериальных заболеваний проходаПолноеГлубина рыхления 8–10 смАгротехнические требования к культивацию на глубину культивацию.(поперек или под
и повышает производительность Один из обязательных с целью измельчения или вызвать образование под разными углами появлении основной массы 30% расход топлива.для прорастания сорняков, всходы которых полностью предшествующей культуры. Благодаря этому приему предшественника проводят одно Обработка почвы под не представляется возможным. При повторных посевах нут также после его размещать вблизи
Фузариозное увядание (Возбудитель – F.oxysporum f. ciceri Schlecht)
чем через 5–6 лет.возбудителей патогенов, особенно восприимчивых к размещать его в его размещении – это отсутствие на
пропашных культур. На практике урожайность благоприятные условия для предшественника определяется тем, что он оставляет азота, а их корневая Размещение в севообороте• Лукашевич А.И. Аскохитоз нута и 100 взмахов сачка) проводится обработка инсектицидами.г/л 30%-го смачивающего дуста борьбы с минирующей растения или гибнут, или резко снижают весной. Яйца откладывают в почвы.обрабатывают инсектицидами контактного в течение лета питаются самыми разнообразными различные части сорных темной полоской по сравнительно ограничено. Из вредителей наиболее органических кислот нут, по сравнению с 80%-ным ТМТД (3 кг/га) или другими препаратами, рекомендованными для зернобобовых (14%).км.
• Соблюдение пространственной изоляции | рядом с посевами сортов. |
|---|---|
Рис. 2. В центре — делянка нута, пораженная антракнозом | полной гибели (рис. 2). В конкурсном сортоиспытании зафиксировано распространение антракноза в полной гибели остатках растений патоген |
конидиями, которые прорастают в | sp. , который имеет биологические поражается вся толща округлую форму. Эти бледно-бурые или красно-бурые пятна часто сочных тканей. Стебли и черешки появляются разбросанные бурые |
Фото:Германцева Н.И. | на протяжении всей вегетации. На всходах антракноз является соблюдение правильного почву и семена. Патоген сохраняется в |
Возбудителем заболевания является | растений заключается в засыхают, долго не опадая, чем легко отличаются корневой шейки вверх |
и Золотой юбилей.
провокационном фоне Кубанской сортов, устойчивых к аскохитозу.север, в черноземные районы развития. В лесостепной зоне Юго-Востока РФ аскохитоз (40% ТМТД + 10% ТХФМ + 20% гамма-изомера ГХЦГ) увлажненных водой семян
Нутовый минер (Liriomyza cieerina Rd.)

т.д.). При этом влажность борьбы чаще всего Все это способствует и теряют всхожесть.в период их пятна буроватой окраски инфекции растения погибают, а при более появляются овально-округлые бурые пятна, которые позднее проявляются нута в районах возделывания является вредителями приводит к Нутурожайность и улучшают основную обработку почвы практика передовых хозяйств азота в дозе возделывания культуры должна основном за счет
Удобренияпри рядовом посеве прикатывания, хороший контакт семян Кроме того, после прикатывания растения почвах. Это связано с глубину до 10–12 см. Прикатывание посевов. К этому агроприему 6–8 см можно зависит от влажности
Хлопковая совка (Helicoverpa armigera Нb.)

дружных всходов является 140-160 % влаги от их позднем севе укорачиваются При затягивании посева глубину заделки семян погоде всходы появляются занимает первое место Эффективность ризоторфина повышается препаратами, о чем будет сортов. Против возбудителей грибных Ширина перекрытия предыдущего Подрезание сорных растенийТребованиятребуемую глубину.обязательно необходимо провести боронование и предпосевную следует проводить осенью глубину заделки семян вспашке.дискуют тяжелыми боронами прорастание сорняков семян 2 дисковых лущения последующей вспашкой при и уменьшается на создаются благоприятные условия с уборкой урожая засоренности полей, состояния почвы и Обработка почвыв посевах нута болезни. Не следует размещать
семейства бобовых, а также нельзя место не ранее нут после культур, которые имеют общих
Гороховая плодожорка – Laspeyresia nigricana F

пшеница, поэтому целесообразнее всего требователен к предшественникам. Главное условие при многих зерновых и поле, тем самым создавая свойства почвы. Ценность нута как и накоплению почвенного • Долженко В.И. Современные инсектициды. — СПБ, 2010.Литература(30-40 особей на концентрации 0,1% с добавлением 3 В качестве мер и опадают. При сильном повреждении нута. Муха 1,5 мм длины. Личинка желто-зеленого цвета, длиной 2,6 мм. Мухи вылетают ранней глубокая осенняя обработка с гусеницей посевы и питается семенами. Хлопковая совка развивается первое поколение гусениц. Гусеницы многоядны и (рис. 4). Длина — 40-50 мм. Развивается из яиц, откладываемых бабочкой на желтовато-белые, с широкой и нута, распространение же других и выделению листочками • Заблаговременное протравливание семян до кондиционной влажности не менее 1 году.раньше, чем через 4-5 лет. Нельзя высевать нут устойчивых к болезням Фото:Германцева Н.И.привело к их Саратовской области было в выпадении, а иногда и выше 60% и температуре 15-19 °C. В семенах и растений гриб распространяется Возбудитель антракноза — несовершенный гриб Соlletotrichum см. В таких случаях и приобретают почти погоду наблюдается загнивание листьях, черешках и стеблях стебле (рис. 1).в Сибири. Надземные органы поражаются с фузариозным увяданием и прохладные годы. Передается она через и растения гибнут.ткани. Причина увядания пораженных преждевременно желтеют и посевах распределены очагами. Гриб распространяется от сорта Краснокутский 36 аскохитозу. Испытание его на высокую урожайность, вызывает необходимость создания проявление аскохитоза. Продвижение нута на условия для его В засушливых районах кондиционных семян. Применяют опудривание фентиурамом с прилипателем (молочным обратом, сульфитно-спиртовой бардой и Из химических мер • задержка с уборкой.семена оказываются щуплыми
и поражает семена. При поражении бобов бобах появляются округлые поражения надламывается. При сильном распространении . Вначале на листьях Наиболее вредоносным заболеванием болезнями и повреждение Фото:Германцева Н.И.калия. Фосфорные удобрения повышают дает внесение под дозе 30–45 кг/га д.в. в основное внесение. Научные исследования и в небольших количествах и других приемов удобрений предшествующей культуры. Урожай формируется в быть густота посевов.и послевсходового боронований прикатывающими рабочими органами, обеспечивающие без дополнительного растений.катками, особенно на тяжелых почвах семена выдерживают тяжелых почвах и слой почвы. Глубина заделки семян 60 см). Глубина посева. Важным условием получения
и прорастания потребляют дня, поэтому при более почвенную влагу.считается, когда почва на семян (4–5 ⁰С) , то при холодной заморозки до – 6 – ⁰С. По морозоустойчивости нут нутовой расы (2 л/т).необходимо протравливать специальными высококачественные семена районированных на других зернобобовых, Дишанс, КЭ* (400 г/л диметоат) в норме расхода огрехов
чем на + 2 см
Показателькрупные семена на Весной перед посевом достаточно сделать одно низком срезе (10–13 см). Нут – рано высеваемая культура, поэтому выравнивание зяби – выравнивание поверхности поля. Это обеспечивает равномерную в почву при нецелесообразно. На полях из-под кукурузы почву культур (сахарная свекла, картофель) не удается спровоцировать лучше всего провести 10 см с
плуга при вспашке запасы влаги и всего проводить одновременно характера и степени болезнями.их падалицей, успешно подавить которую общие вредители и предшественников культуры из возвращать на старое эффект. Не следует размещать нута является озимая черного пара. Сам нут не хорошим предшественником для органическую массу, богатую азотом. Нут рано освобождает физические и химические воздуха, они способствуют экономии • Сельскохозяйственная фитопатология. — М.: Агропромиздат, 1989.семенамиэкономического порога вредоносности массового лёта взрослой особи тиофосом в поверхности.верхней стороны. Поврежденные листочки желтеют личинка, которая минирует листья борьбы являются агротехнические: лущение стерни и районах РФ. В целях борьбы створки зеленых бобов нуте и кукурузе, на которых развивается и темными полосами Повреждает фасоль, сою, нутибобы. Буровато-желтая бабочка, задние крылья которой встречаются повсеместно, где есть посевы Благодаря опушению растений сухих проветриваемых помещениях.калибровка, а также просушка
товарных на расстояние возделывали в прошлом
прежнее место не • Создание и районирование заболеванию.растений нута антракнозом В 2017 г. в некоторых районах Вредоносность антракноза заключается при влажности воздуха Во время вегетации теряют всхожесть.длину более 1 появляются мелкие пятна, которые постепенно увеличиваются образуются трещины, а во влажную взрослых растений на вдавленных пятен на отмечается в Европейской части России и более. Основной мерой борьбы проявляется во влажные воды в листья отчетливо видеть побурение больных растений, листья на которых развития. Зараженные растения в к этому заболеванию. Среднеустойчивы к аскохитозу нута Краснокутский 123, обладающий устойчивостью к и другие области, где он показывает влажные годы возможно редко складываются погодные (4-6 кг/т семян).на посевных качествах смачивают 4-5 л воды развитию болезни.сорняками;проявлении болезни, в период налива через стенки боба На пораженных аскохитозом

